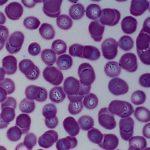

Causes d'infection et symptômes de la babésiose chez les bovins, méthodes de traitement et de prévention
La babésiose bovine est comprise comme une pathologie courante de nature invasive. Il se trouve dans diverses régions et peut entraîner de graves pertes et la mort d'un grand nombre de têtes de bétail. Par conséquent, il est si important de faire face à la prévention de la maladie en temps opportun. Si ses symptômes apparaissent, il est recommandé d'isoler immédiatement l'animal malade et de prendre des mesures pour le traiter.
Description de la maladie
La babésiose est une maladie invasive dangereuse associée à des lésions des tissus et des organes des animaux par les protozoaires. Les babésies parasites sont considérées comme très dangereuses. Ces micro-organismes se sont répandus presque partout sur la planète. La seule exception est l'Antarctique. La maladie est caractérisée par de vagues symptômes. Elle est souvent identifiée à la piroplasmose.
Causes et symptômes de la maladie
Les parasites assez gros sont considérés comme les agents responsables de la pathologie. Ils peuvent être de différentes formes. Cependant, la plus courante est la pyriforme. Les parasites envahissent généralement les cellules sanguines. En conséquence, de puissantes substances toxiques s'accumulent dans le corps, ce qui l'empoisonne.
Le principal vecteur de la maladie est considéré comme étant les tiques parasites du genre Ixodes. Par conséquent, il est généralement saisonnier et associé à la période de développement de masse des tiques. Le pic d'activité des insectes se situe en juin-juillet. Presque tous les membres du genre propagent un agent pathogène spécifique.
Tout d'abord, la maladie se manifeste sous la forme de lésions complexes du système nerveux et de dysfonctionnements des organes et des systèmes. L'agent pathogène est assez contagieux. Par conséquent, la babésiose ne peut être évitée sans une prophylaxie annuelle. Chez les bovins, la pathologie provoque les symptômes suivants:
- diminution de la production de lait et diminution de l'appétit;
- une augmentation de la température corporelle jusqu'à 40-42 degrés, un état fébrile;
- pâleur des muqueuses - elles acquièrent rapidement une teinte jaune;
- couleur rose de l'urine - à la fin de la maladie, elle devient rouge foncé;
- arrêt de la traite pendant 4 à 6 jours;
- composition sanguine aqueuse.

Diagnostiquer le problème
Pour poser un diagnostic, une approche globale est utilisée. Pour cela, il convient de considérer le tableau clinique, les résultats de l'examen microscopique des frottis. Les méthodes de diagnostic sérologique sont considérées comme informatives.
Comment traiter la babésiose chez les bovins
Lorsque la babésie est détectée dans le corps, il est important de prendre des mesures immédiates. Le parasite provoque une défaite rapide et provoque des changements négatifs dans les organes et les systèmes. Dans ce cas, les animaux affectés meurent souvent. Par conséquent, aux premiers symptômes de la pathologie, l'animal a besoin de paix et de confort. Il est recommandé de le nourrir correctement et de lui donner des agents antiparasitaires.
Tout d'abord, l'animal doit bénéficier d'un repos complet et l'isoler des autres animaux. Une activité accrue et une activité physique prolongée affectent négativement l'état général de l'animal. Cela affecte négativement l'état du système immunitaire. En conséquence, il y a une augmentation des lésions invasives. Pour isoler les animaux affectés, ils sont déplacés dans une pièce lumineuse. Dans ce cas, la température doit être d'au moins +15 degrés. L'humidité relative ne peut pas dépasser 85%. Les principaux remèdes pour le traitement de la babésiose comprennent:
- "Azidin-vet" - le médicament est administré par voie intramusculaire ou sous-cutanée. Il doit être entré 1 fois. Si l'état ne s'améliore pas, une deuxième injection est administrée après 24 à 30 heures.
- "Acaprin" - la composition est utilisée pour les injections intramusculaires ou sous-cutanées. L'agent doit être administré sous la forme d'une solution aqueuse à une concentration de 1%.
- "Hemosporidin" - le médicament convient à une administration sous-cutanée ou intramusculaire. Dans ce cas, une solution aqueuse à 1 à 2% est utilisée. Il est recommandé d'administrer la substance 2 à 3 fois à des intervalles d'une journée.
- «Imidocarbe» - injecté par voie intramusculaire ou sous-cutanée. L'outil est utilisé 1 fois. Si l'état ne s'améliore pas, l'administration doit être répétée après 1 à 2 jours.

Les agents supplémentaires utilisés pour traiter le bétail sont les suivants:
- Albargin est un puissant agent antiparasitaire à effet complexe. Le médicament est administré 1 fois par injection intraveineuse.
- Vitamine B12 - utilisée pour stimuler les fonctions hématopoïétiques. La composition est adaptée à l'injection. 1 animal a besoin de 1 à 2 milligrammes de substance. Il est recommandé d'utiliser le médicament pendant plusieurs jours jusqu'à ce que la structure sanguine s'améliore.
- Sel de Glauber - améliore l'état du corps avec le développement de l'atonie ventriculaire. Le médicament est utilisé sous la forme d'une solution à une concentration de 1%. La substance est lavée de la cicatrice à l'aide d'un tube gastrique.
- La caféine est utilisée pour normaliser les fonctions du cœur et des vaisseaux sanguins. La substance convient à une injection sous-cutanée. Pour cela, il vaut la peine d'utiliser 5 à 10 millilitres pour 1 personne par jour. Il est recommandé d'administrer la solution une fois. Si nécessaire, la procédure doit être répétée.
- Chlorure de sodium - utilisé pour lutter contre l'atonie persistante du proventricule. Le produit convient à une administration intraveineuse. Dans ce cas, il est recommandé d'utiliser des solutions aqueuses de concentration 10%. Pour 1 personne, 200 à 300 millilitres sont nécessaires. La durée du traitement dépend de la gravité de la maladie. Cela prend généralement plusieurs jours.
Pour que le traitement soit efficace, il est important de fournir à votre bétail une alimentation correcte et saine.
À ce moment, le corps de l'animal a besoin de vitamines, de minéraux et d'autres éléments bénéfiques qui activent le système immunitaire.
Pour cela, il est recommandé d'utiliser du foin haché d'herbes de prairie, d'herbe verte, de racines fraîches. Pour améliorer la condition des animaux, du lait frais ou inversé convient. Il est recommandé d'utiliser ce type d'alimentation 3 fois par jour. 1 animal aura besoin de 1,5 à 2 litres.
Mesures préventives
Pour éviter le développement d'une pathologie, il est recommandé de respecter les règles suivantes:
- faire paître le bétail sur des pâturages éprouvés et protégés des tiques;
- garder le bétail dans une stalle;
- surveiller l'apparence et garder les animaux propres;
- pendant le développement de masse des tiques, traiter les couvertures extérieures tous les 10 jours avec des acaricides - ceux-ci incluent "Perméthrine", "Butoks";
- dans les régions avec une situation défavorable au début du développement de masse des tiques, une fois administré «Azidin-vet» ou «Hemosporidin».
Est-ce dangereux pour les humains
Chez l'homme, cette pathologie se développe généralement dans le contexte d'un système immunitaire affaibli. De plus, de tels cas sont extrêmement rares. Avec une immunité normale, la maladie est asymptomatique.
La babésiose est l'une des infestations parasitaires les plus complexes qui surviennent souvent chez les bovins. Chaque année, la pathologie s'étend à de vastes zones. Par conséquent, les animaux malades se trouvent partout. Pour faire face à la maladie et éviter la mort du bétail, il est important de prendre des mesures en temps opportun.